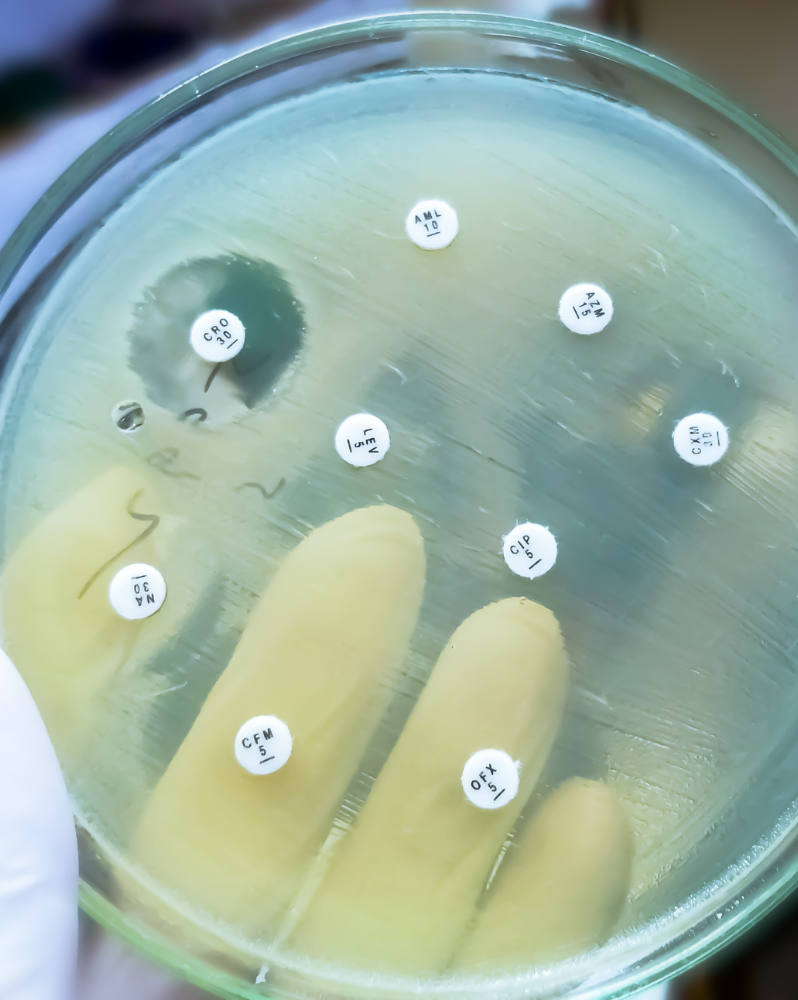
Antimicrobial susceptibility testing in petri dish

Antibiotics and sputum
PCRS position statement
PCRS advocates that:
- All healthcare professionals have a duty to maintain antibiotics stewardship;
- Healthcare policy makers need to invest in ways to ensure antibiotics are prescribed appropriately;
- Antimicrobial stewardship should be a measure of quality of healthcare service provision;
- Commissioners should prioritise measures that improve decision-making regarding antibiotic prescribing;
- Research into all respiratory infection especially tuberculosis (TB) and multidrug-resistant TB (MDR-TB) should be supported;
- There should be increased public awareness and education around antimicrobial resistance (AMR) and the risks associated with this; and
- There should be further research and development of guidelines on the best practice in prescribing antibiotics and the importance of sputum for managing respiratory infection in primary care setting.
| Attachment | Size |
|---|---|
| Antibiotics and sputum | 124.46 KB |
You may also be interested in...
PCRS work through campaigns, advocacy and partnership to promote best practice to help improve outcomes for people living with respiratory symptoms and illness in the UK. We are the voice representing respiratory expertise across primary and community care, influencing national policy and the development of quality standards.